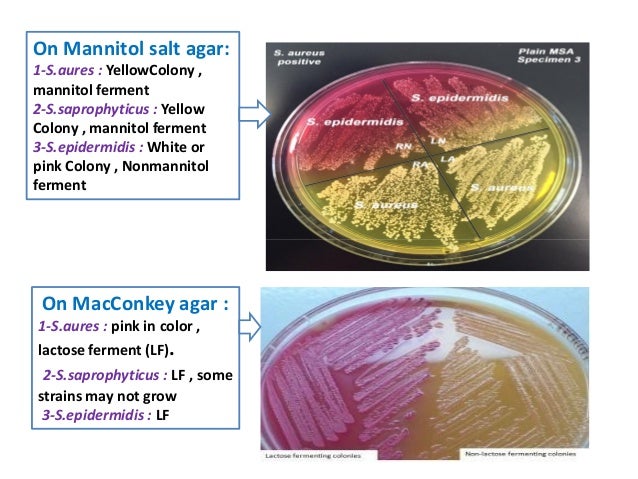

S Aureus Msa Plate

Cultivation Media For Bacteria
2

Ppt Selective And Differential Media Powerpoint Presentation Free Download Id

Mannitol Salt Agar Test

Pin On Science Nature

Mannitol Salt Agar Msa Results Theory Youtube
_(1).jpg?bwg=1562148427)

Lab 3 At Loma Linda Academy Studyblue
Http Citeseerx Ist Psu Edu Viewdoc Download Doi 10 1 1 922 2657 Rep Rep1 Type Pdf
Biol 230 Lab Manual Staphylococcus Epidermidis On Mannitol Salt Agar

Mannitol Salt Agar

Staphylococcus Mannitol Salt Agar Plate Medical Laboratories

Isolation And Identification Of Gram Positive Cocci Ppt Video Online Download

Msa With Oxacillin Mannitol Salt Agar With 6 5 Sodium Chloride And 4mcg Ml Oxacillin Hardy Diagnostics Vwr

Mannitol Salt Mannitol Salt Agar Msa 15x100mm Biplate 10 Pk

Staphylococci Prac Microbiology
Http Www Interchim Fr Ft J Jh992a Pdf
Q Tbn 3aand9gcq0fb7kqcd3bewi3vuqqhupwlp4bqj Qjkilrelsirym2lkqaox Usqp Cau

Mannitol Salt Agar Nutrient Agar Growth Medium Png Pngwave
1

The Belly Button Can Act As A Reservoir For Staphylococcus Aureus Cleaning The Area With Chlorhexidine Can Reduce And Possibly Eliminate Its Presence Staphacne

Solved Below Are The Results For Two Different Differenti Chegg Com

Mannitol Salt Agar Msa Composition Uses And Colony Characteristics Learn Microbiology Online

Mannitol Salt Agar Msa Chapman Medium European Pharmacopoeia Usp Cat Nº 1062

Selective Differential Media Flashcards Quizlet

Mannitol Salt Agar Msa For The Identification Of Staphylococcus Aureus And Epidermidis

Pht 313 Lab 1 Staphylococci Ppt Video Online Download

Mannitol Salt Agar Msa Test Scientist Cindy

Mannitol Salt Agar Msa Images Stock Photos Vectors Shutterstock

Mannitol Salt Agar Msa

22a Identification Of Staphylococcus Species Biology Libretexts
Prevalence Of Methicillin Resistant Staphylococcus Aureus In Shrines

Mannitol Salt Agar Msa Composition Uses And Colony Characteristics Learn Microbiology Online

Microbiology Lab Molb 2210
_(1).jpg?bwg=1562148427)
Micr350 Streaked Images

Staphylococcus Aureus And Staphylococcus Epidermidis On Mannitol Salt Agar Mannitol Salt Agar Composition Positive And Negative Result On Mannitol Salt Agar

Mannitol Salt Agar Msa Plate Inoculated With Staphylococcu Flickr

Mannitol Salt Agar Msa Mycrobe

Mannitol Salt Agar Msa Youtube

Mannitol Salt Agar Msa Test Scientist Cindy
Http Www Thistle Co Za Pdf Files Education Microbiology Microbiology Legends Cycle 29 Cycle 29 organism 3 Staph saprophyticus Pdf

Mannitol Salt Agar Msa Plate

How To Interpret Mannitol Salt Agar Bacterial Growth Medium Youtube

Experiment 8c Lab08 Virtual Edge Molb 21 College Of Agriculture And Natural Sciences

Mannitol Salt Agar Microbiology Food And Drug Reference

Typical Golden Yellow Colonies Of Staphylococcus Aureus On Mannitol Download Scientific Diagram

Cultivation Media For Bacteria

Mannitol Salt Agar Chapman Medium Staphylococcus Aureus And Staphylococcus Epidermidis Colonies On Mannitol Salt Agar Plate

Mannitol Salt Agar Msa For The Identification Of Staphylococcus Aureus And Epidermidis

Ppt Isolation And Identification Of Staphylococci Powerpoint Presentation Id

Growth Of Staphylococcus Aureus On Mannitol Salt Agar Download Scientific Diagram
Mannitol Utilisation Is Required For Protection Of Staphylococcus Aureus From Human Skin Antimicrobial Fatty Acids

Mannitol Salt Bacterial Growth Medium Msa
_(1).jpg?bwg=1562148427)
Micr350 Streaked Images

Asmscience Mannitol Salt Agar Plates Protocols

Mannitol Salt Agar Plate Test Composition Preparation Uses Laboratoryinfo Com

Mannitol Salt Agar Microbiology Images Photographs From Science Prof Online
Staphylococcus Aureus On Mannitol Salt Microbiology Laboratory Turkey Facebook
Pdfs Semanticscholar Org 8ffc Efaafac0d327c35e908f7d93bd468c Pdf
Www vmc Org Data Files Case Study Burnham staph pseudintermedius student materials Pdf

Solved 25 Bacteria Have Been Inoculated On This Mannitol Chegg Com

Mannitol Salt Agar Msa Composition Uses And Colony Characteristics Learn Microbiology Online

Hardy Diagnostics Mannitol Salt Agar Msa Usp For Staphylococcus 15x100mm Plate Order By The Package Of 10 Science Lab Agar Media Amazon Com Industrial Scientific

Medical Laboratory And Biomedical Science Staphylococcus Aureus On Msa Plate

Metabolism Physiology And Growth Characteristics Of Cocci Microbiology A Laboratory Experience

Selective Growth Of Staphylococcus Aureus From Flushed Dairy Manure Wastewater Using Acriflavine Supplemented Mannitol Salt Agar Davis 06 Letters In Applied Microbiology Wiley Online Library

Microbiology Lab Molb 2210

Mannitol Salt Agar Msa Test Scientist Cindy

Name Date Mannitol Salt Agar Plate Msa Your Result Chegg Com

Mannitol Salt Agar Microbiology Food And Drug Reference

Mannitol Salt Bacterial Growth Medium Msa Page 2

Welcome To Microbugz Mannitol Salt Agar

Mannitol Salt Agar Msa Plate

Mannitol Salt Agar Msa Introduction Composition Preparation Uses And

Yellow Colonies Of S Aureus On Mannitol Salt Agar Download Scientific Diagram

Mannitol Salt Agar Microbiology Images Photographs From Science Prof Online

Antibiotics Free Full Text The Continuing Threat Of Methicillin Resistant Staphylococcus Aureus Html

Microbiology Lab Report 3

Media Examples With Pics Flashcards Quizlet

Lab 5 Integumentary System Bacteriology And Identification Ppt Download

Microbiology And Beauty What Has Been Made

Sciencefurry Instagram Posts Photos And Videos Picuki Com

Types Of Culture Media Pptx 2
1

Mannitol Salt Agar For The Isolation Of Staphylococcus Aureus

Mannitol Salt Agar Microbiology Food And Drug Reference

Asmscience Mannitol Salt Agar Plates Protocols

Staphylococcus Epidermidis On Agar Plate With Mannitol Salt Agar Chapman Agar Growth Of S Epidermidis In Petri Dish On Chapman Agar Medium Appearance And Morphology Of Staphylococcus Epidermidis And S Aureus Colonies On Mannitol

I Ve Attached Lab Worksheets And Images Phenylet Chegg Com

Mannitol Salt Agar Wikipedia

Mannitol Salt Agar Msa Usp For Staphylococcus 15x100mm Plate 10 Pack By Hardy Diagnostics Emerald Scientific

Pin On Micro

Micro Lab Practical 3 Flashcards Quizlet

What Is Mannitol Salt Agar Biology Wise

Mannitol Salt Agar Plate Test Composition Preparation Uses Laboratoryinfo Com

Staphylococcus Aureus Bacterial Pathogenesis
Q Tbn 3aand9gcr Az56eihwxq5vuw Bjcwlvg5zklbazpreovl1mxlwkmiggvar Usqp Cau

Msa Plates Depicting Cfu Of S Aureus Unchallenged Culture A And Download Scientific Diagram

Isolation Of Foodborne Pathogens On Selective Differential And Enriched Medium By Streak Plating Springerlink

Growth On Mannitol Salt Agar Media Showing Presence Of Yellow Halo Download Scientific Diagram

Mannitol Salt Agar Msa Test Superfarmer S Weblog

Isolation Identification Of Staphylococci Ppt Video Online Download

Mannitol Salt Agar Li 30ml Application Isolation And Presumptive Identification Of Staphylococcus Aureus In Non Sterile

Mannitol Salt Agar
Staphylococcus